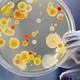
Segment microbiology

-
Water is discovered on the Moon
-
Mercury is 98% mapped
-
Major breakthrough in cancer research
-
Scientists extract images directly from the brain on December 14
-
Arctic sea ice extent hits a record low
-
Pluto is demoted to "dwarf planet" status
-
North Korea conducts its first nuclear test on October 9
-
The West African black rhino is declared extinct
-
Graphene is isolated
-
NASA's twin robot geologists landed in Mars
-
The Human Genome Project is completed
-
Chinese Astronaut Yang Liwei and the Shenzhou V capsule on October 15
-
The dwarf planet Quaoar is discovered
-
Space station Mir is deorbited
-
The Pyrenean Ibex goes extinct
-
A list shows items. A timeline shows sequence.
Use Timetoast to make dates, milestones, and turning points easier to understand in a clear visual format. Timetoast is a timeline maker for work, school, research, and stories.